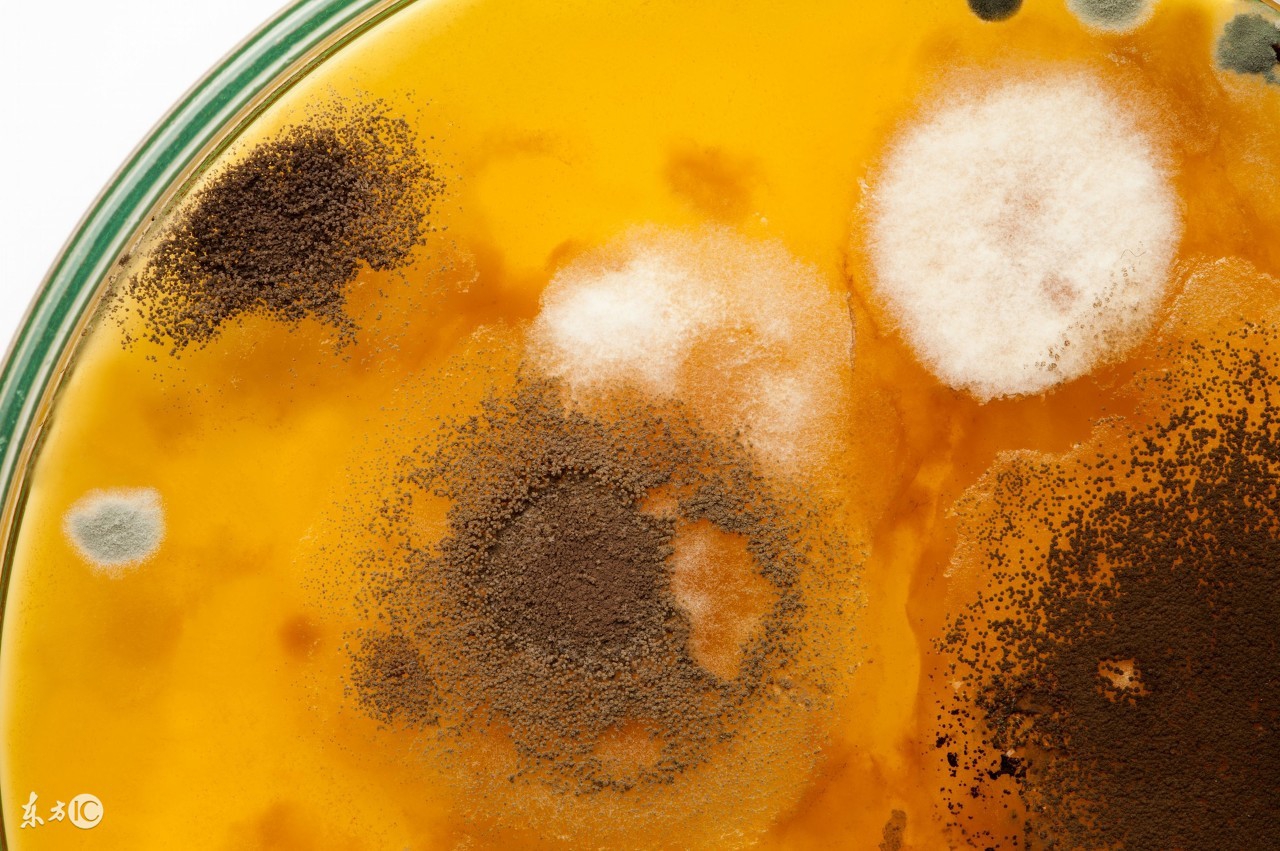
霉菌毒素对猪场影响,养猪场霉菌用什么消毒

每年养猪场除了各种流行性的疾病外,其实还应该注意一个病——霉菌中毒,这是个从口入的疾病,而且危害还特别的大,所以一定要注意经常防范,不但是饲料的存放还有玉米、豆粕等大料的添加。
霉菌毒素防范必须常态化
霉菌是形成分枝菌丝的真菌的统称,其对环境条件不苛刻,繁殖能力极强,饲料是霉菌天然的优质培养基,主要依靠无性或有性孢子繁殖。动物吃进被真菌污染的饲料、饲草致病,称真菌毒素中毒病。霉菌广泛存在于空气、土壤、水及腐败的有机物中。饲料霉变及霉菌毒素污染是一个持续性的全球性严峻问题。饲料原料、运输工具、饲喂工具、大型料仓、料线、潮湿圈舍等受霉菌毒素污染的风险很高。日粮中缺少蛋白质、硒和维生素是霉菌毒素中毒的易感因素,饲料发生霉变是霉菌中毒的根本原因。全球每年大约25%的谷物受霉菌毒素污染。我国饲料霉变问题则尤其突出,如玉米、稻谷、小麦、油菜等饲料霉菌毒素污染率高达90%以上,严重污染而至禁用程度的则高达20%左右。基于此,任何一家饲料企业的任何一款饲料产品、任何一个畜禽养殖场,尤其是自配料养殖场,均会在不同时段受到不同程度的霉菌污染或威胁。

霉菌毒素对动物的危害(罗列几种)
黄曲霉毒素:危害最严重,最强免疫抑制而破坏免疫系统;凝血因子*制剂抑**,损伤组织器官易渗血; 侵害肝脏致肝损伤,降低解毒与消化功能。
赤霉烯酮:生长在玉米、高粱和小麦上,具雌激素作用。不同剂量引致不同病状,母畜性早熟、外阴红肿、黄体滞留、不发情、假妊娠、早期胚胎死亡、流产;公畜性欲低下、包皮浮肿、*丸睾**萎缩、死精。还可致少乳、无乳、腹泻、脱肛、黄疸、出血、淤血。
赭曲霉毒素:霉菌肾毒素,致动物腹泻、厌食、脱水、生长迟缓、饲料利用率低,剖检肾苍白坚硬即橡皮肾。
新月霉毒素:引致瘙痒、皮肤坏死、淋巴系统损伤、胃肠炎、厌食,严重则致动物拒食、呕吐、衰竭。
麦角毒素:动物精神沉郁、采食减少、后腿跛行,严重者尾巴、耳朵和蹄坏死。
镰孢霉素:普遍存在于玉米中,可致动物咳喘、呼吸困难、肺水肿、胸腔积液,发病率高达50%,病死率50-90%。

饲料原料和全价料中经常同时存在几种霉菌毒素,且毒素之间相互协同,使动物中毒时临床症状更复杂、更严重。有时很少能见到每种毒素的特征性临床症状,如玉米赤霉烯酮的外阴红肿、烟曲霉毒素的呼吸急促等。当前动物霉菌毒素中毒综合征有四大特点:一是多见多种霉菌毒素联合致病的症候群;二是中毒综合症多属慢性中毒;三是出现如眼结膜红肿外翻、石灰样尿石症等新症状;四是多系统、多器官病变;五是肢蹄跛行、后躯瘫痪、呕吐、外八字型行走。

霉菌中毒综合预防措施
一、严控霉变饲粮当做饲料原料:从原料的采购、储存、加工玉米、小麦、高梁、稻谷、麸皮、蚕蛹、鱼干等水分不得超标,防止饲料原料全程全环节发霉变质;严格“先进先出”并及时清理已被污染的原料;严重发霉的饲料要全部废弃,绝对禁止饲喂。
二、适时有效脱毒处理:淘洗、烘干、过筛、风车、除杂、除尘、膨化;饲料加工中全程按0.1%添加霉速清或霉毒清;动物日粮中长期按0.2%添加肝平克、霉毒消、霉毒清、霉速清、激抗、益生肽。霉菌毒素处理剂或吸附剂质量千差万别,有蒙脱石等硅铝酸盐类吸附剂、有甘露寡糖类、有双极性改性水合硅铝酸盐、有中药提取物等,应注意甄别比你选用合格优质的脱霉剂类产品。

动物霉菌毒素中毒后的控制
动物霉菌毒素中毒目前无特效药物治疗。一旦发生,立即停用含霉菌毒素的饲料及原料,更换无毒饲料并在全群饲料中按0.3%添加霉毒清或霉速清等霉菌毒素处理剂,同时按0.5%添加螯合参华素、肝平克等。

亲爱的养殖朋友们关注微信公众号:(恒辉生物 / hhsw68),可以学习到养殖管理,行情分析,发酵产品咨询,疾病防治,政策解读等,如有所需我们会有专业老师第一时间给你回复!